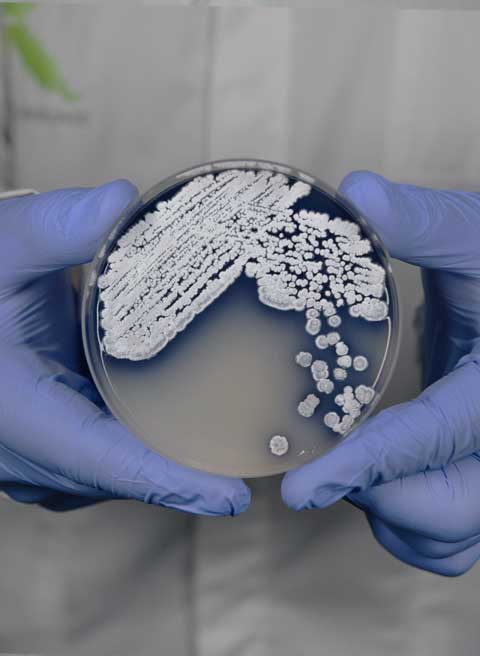
Biopigmenta

of Color
is Alive.
Mission
Biopigmenta is your partner in designing biobased products
Biopigmenta harnesses the power of bacteria to create vibrant, eco-friendly pigments. We are pioneering the use of bacterial pigments to create a sustainable future in the printing and dyeing industries.
MoreProducts
Pigmented bacteria
For interested third parties, we provide access to our meticulously curated catalogue of pigmented bacterial strains. Each strain has been extensively characterized from a microbiological, biochemical, and genetic standpoint, ensuring a deep understanding of its properties and potential.
Bacterial Dyeing
Experience the future of sustainable textile coloration with our innovative bacterial dyeing service, which utilizes live bacterial cultures to imprint vibrant hues onto fabrics.
Bacterial Pigments for Printing
Unleash your creativity with our versatile palette of ready-to-use bacterial pigments, specifically formulated for screen printing applications on various substrates.
 